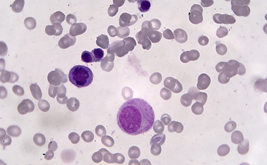

TrueChrome Metrics (HDMI)
Showcase

Color Tissue Section TrueChrome Metrics
Color Tissue Section TrueChrome Metrics
![]() 2015-12-05
2015-12-05

BPAE cell FL Image-TrueChrome Metrics
BPAE cell FL Image-TrueChrome Metrics
![]() 2015-12-05
2015-12-05

FL Image-TrueChrome Metrics
FL Image-TrueChrome Metrics
![]() 2015-12-05
2015-12-05
Blood Cell Image-TrueChrome Metrics
Blood Cell Image-TrueChrome Metrics
![]() 2015-12-05
2015-12-05
Videos























